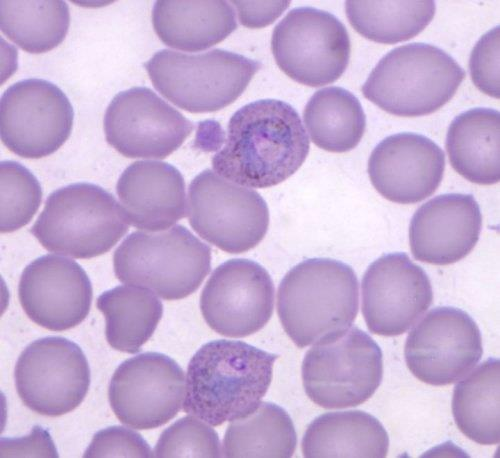

1/31
Looks like no tags are added yet.
Name | Mastery | Learn | Test | Matching | Spaced |
|---|
No study sessions yet.
Trichomonas vaginalis

Giardia lambia

Giardia lambia cysta

Trypanosoma brucei gambiense

Trypanosoma cruzi

Entamoeba histolytica trofozoit

Entamoeba histolytica cysta

Plasmodium vivax
Toxoplasma gondii

Schistosoma haematobium

Schistosoma haematobium furkocerkaria

Taenia saginata skolex

Taenia saginata człon maciczny

Taenia solium skolex

Taenia solium człon maciczny

Taenia spp. jajo

Echinocococcus granulosus protoskolex

Ascaris lumbricoides

Ascaris lumbricoides jajo

Trichuris trichiura jajo

Trichuris trichiura samiec

Trichuris trichiura samica

Enterobius vermicularis

Enterobius vermicularis jajo

Trichinella spiralis

Ixodes ricinus

Demodex folliculorum

Sarcoptes scabei

Pediculus humanus

Pthirus pubis

Cimex lectularius

Pulex irritans
